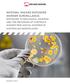
NATIONAL HAZARD EXPOSURE WORKER SURVEILLANCE:

IMAGE ASSISTANT: DERMATOMYCOSES
|
|
|
- Edith Berry
- 10 years ago
- Views:
Transcription
1 IMAGE ASSISTANT: DERMATOMYCOSES Summary: The Image Assistant has been developed to provide medical doctors with a software tool to search, display, edit and use medical illustrations of their own specialty, so that they can print, and include them in medical presentations (e.g.: a PowerPoint presentation or a poster). Illustrations have been carefully selected in order to cover the doctor s medical specialty and are meant as a contribution to doctor-patient communication. 1
2 Sections of the image assistant software: 1. Image Assistant: It allows searching and editing (adding texts, arrows, lines, etc.) medical illustrations. Edited images can be saved and reused later. All of them can be copied to the Clipboard to Copy/Paste on other applications or print them; also, they can be ed directly from the application itself. Thus, the doctor can use and/or send any illustration to a patient or colleague in a few seconds. 2
3 2. Interactive anatomy: It includes 3D animations on different organs and interactive illustrations in layers (magnifier effect) on the specialty of each title. 3. Laboratory normal values and test data of frequent use: Tables with laboratory reference range values of frequent use are included to be used by doctors when needed. 3
4 4. Product information: Here, the Sponsor laboratory may include product packaging pictures, videos, animations, information for prescription and medical studies. These studies may be either Word or PDF text files. All the information included in this section will be provided by the Sponsor laboratory. 5. Patient database: This section will allow doctors to maintain a database of their patients, add comments on every visit and book appointments. 6. Screen saver: The software also includes an optional Screen Saver with medical illustrations, the current time, a perpetual calendar and a link to the Image Assistant. Upon installation of the application, the option to install the screen saver is offered. When the computer is idle for 10 minutes, the screen saver will appear, showing a calendar of the current month and the current time, and displaying images of the specialty as well as the logo of the sponsor product. 4
5 Development of the image assistant software: 1. Look and feel: The colors and look and feel of the main screen will be customized according to the Sponsor product. 2. Images: Each speciality has its own illustrations and cannot be modified. 3. Delivery time: This interactive program will be delivered in 60 days once we receive the following information: Logo of the company and sponsor product. PDF file with the prescription information. PDF / videos of medical studies to be included. 4. Technical requirements: Windows 98, Windows 2000 or Windows XP. 5
6 Medical images included in this specialty Biology of the Skin and its Appendages The skin organ The horny layer, a keratin skeleton The hair follicle Structure of the hair shaft The hair cycle Nails Skin Microbiology Normal skin flora Normal defenses against infection Pathogenic bacteria of the skin Pathogenic virus of the skin Pathogenic ectoparasites of the skin Pathogenic fungi of the skin Dermatomycoses General characteristics of fungi The fungal cell Superficial Mycoses Dermatomycoses Subcutaneous mycoses Systemic mycoses Opportunistic mycoses Dermatophytes - main genera Dermatophytes - classification Pathogenesis of dermatophytoses Tinea barbae Non-inflammatory tinea capitis. Microsporic tinea by T. tonsurans Non inflammatory tinea capitis. Tinea by Trichophyton tonsurans Tinea capitis Inflammatory tinea capitis (Celsus kerion) Celsus kerion 6
7 Tinea favosa Tinea corporis Tinea cruris Tinea pedis Tinea manuum Tinea faciei Tinea nigra Trichophytic granuloma Onychomycosis, etiology and routes of infection Clinical forms of onychomycosis Onychomycosis Candida albicans and skin involvement Cutaneous candidiases syndrome Candidal intertrigo Diaper rash Tinea versicolor Mixed dermatoses Diagnosis of superficial mycoses Antifungal drugs 7
IMAGE ASSISTANT: OPHTHALMOLOGY
 IMAGE ASSISTANT: OPHTHALMOLOGY Summary: The Image Assistant has been developed to provide medical doctors with a software tool to search, display, edit and use medical illustrations of their own specialty,
IMAGE ASSISTANT: OPHTHALMOLOGY Summary: The Image Assistant has been developed to provide medical doctors with a software tool to search, display, edit and use medical illustrations of their own specialty,
FOX 1064 - Laser Therapy ONYCHOMYKOSIS FUNGAL NAIL INFECTION (ONYCHOMYCOSIS) FOX 1064 nm LASER INNOVATION MA DE IN GERMA NY
 US? G N U F L I A N N A IL S FOX: CLEAR DICATION WITHOUT ME FOX 1064 - Laser Therapy ONYCHOMYKOSIS FUNGAL NAIL INFECTION (ONYCHOMYCOSIS) FOX 1064 LASER INNOVATION MA DE IN GERMA NY FOX Laser offers an
US? G N U F L I A N N A IL S FOX: CLEAR DICATION WITHOUT ME FOX 1064 - Laser Therapy ONYCHOMYKOSIS FUNGAL NAIL INFECTION (ONYCHOMYCOSIS) FOX 1064 LASER INNOVATION MA DE IN GERMA NY FOX Laser offers an
A twenty-year survey of dermatophytoses in Braga, Portugal
 Oxford, IJD International 1365-4632 Blackwell 45 UK Publishing, Journal Ltd, of Ltd. Dermatology 2005 Tropical medicine rounds Dermatophytes Valdigem MISCELLANEOUS et al. in Portugal A twenty-year survey
Oxford, IJD International 1365-4632 Blackwell 45 UK Publishing, Journal Ltd, of Ltd. Dermatology 2005 Tropical medicine rounds Dermatophytes Valdigem MISCELLANEOUS et al. in Portugal A twenty-year survey
7- Doctoral Degree in Public Health and Public Health Sciences (Majoring Microbiology)
 7- Doctoral Degree in Public Health and Public Health Sciences (Majoring Microbiology) Students should fulfill a total of 44 credit hours: 1- Compulsory courses: 14 credit hours. 1504801, 1504802, 1504803,
7- Doctoral Degree in Public Health and Public Health Sciences (Majoring Microbiology) Students should fulfill a total of 44 credit hours: 1- Compulsory courses: 14 credit hours. 1504801, 1504802, 1504803,
ANTIFUNGAL AGENTS. Most common eg. Athlete s foot, Ringworm, and Tinea cruris. Cutaneous = skin, hair and nails
 ANTIFUNGAL AGENTS Objectives: 1. To learn the general classes of fungal infections 2. To learn the subclassification of antifungal drugs 3. To know the mechanism of action and basic uses for antifungal
ANTIFUNGAL AGENTS Objectives: 1. To learn the general classes of fungal infections 2. To learn the subclassification of antifungal drugs 3. To know the mechanism of action and basic uses for antifungal
FUNGAL INFECTIONS OF THE NAILS
 FUNGAL INFECTIONS OF THE NAILS What are the aims of this leaflet? This leaflet has been written to help you understand more about fungal infections of the nails. It tells you what they are, what causes
FUNGAL INFECTIONS OF THE NAILS What are the aims of this leaflet? This leaflet has been written to help you understand more about fungal infections of the nails. It tells you what they are, what causes
Additional details >>> HERE <<<
 Additional details >>> HERE http://dbvir.com/ringworm12/pdx/comw23/ Tags:
Additional details >>> HERE http://dbvir.com/ringworm12/pdx/comw23/ Tags:
Medical Laboratory Technology Program. Student Learning Outcomes & Course Descriptions with Learning Objectives
 Medical Laboratory Technology Program Student Learning Outcomes & Course Descriptions with Learning Objectives Medical Laboratory Technology Student Learning Outcomes All Colorado Mesa University associate
Medical Laboratory Technology Program Student Learning Outcomes & Course Descriptions with Learning Objectives Medical Laboratory Technology Student Learning Outcomes All Colorado Mesa University associate
Course Outline and Syllabus for Students
 Course Outline and Syllabus for Students Name: Ian Crandall Course Number: PHM242H1 Course Title: Microbiology of Infectious Diseases Course Description: The course provides a brief introduction to the
Course Outline and Syllabus for Students Name: Ian Crandall Course Number: PHM242H1 Course Title: Microbiology of Infectious Diseases Course Description: The course provides a brief introduction to the
Challenges in prevention and case management of tinea capitis.
 & Challenges in prevention and case management of tinea capitis. An example from a primary school outbreak in 2013. Amber Litzroth, Scientific Institute of Public Health, detached to Agency for Care and
& Challenges in prevention and case management of tinea capitis. An example from a primary school outbreak in 2013. Amber Litzroth, Scientific Institute of Public Health, detached to Agency for Care and
How massage therapists can handle skin conditions, for both themselves and their clients By Annie Morien massage. skin conditions
 How massage therapists can handle skin conditions, for both themselves and their clients By Annie Morien massage skin conditions & Anatomy and Physiology of Skin OVERVIEW. The skin is composed of two distinct
How massage therapists can handle skin conditions, for both themselves and their clients By Annie Morien massage skin conditions & Anatomy and Physiology of Skin OVERVIEW. The skin is composed of two distinct
Course Descriptions. I. Professional Courses: MSEG 7216: Introduction to Infectious Diseases (Medical Students)
 Course Descriptions I. Professional Courses: MSEG 7216: Introduction to Infectious Diseases (Medical Students) This course is offered during the first semester of the second year of the MD Program. It
Course Descriptions I. Professional Courses: MSEG 7216: Introduction to Infectious Diseases (Medical Students) This course is offered during the first semester of the second year of the MD Program. It
STATE UNIVERSITY OF NEW YORK COLLEGE OF TECHNOLOGY CANTON, NEW YORK COURSE OUTLINE VSCT 210 VETERINARY MICROBIOLOGY
 STATE UNIVERSITY OF NEW YORK COLLEGE OF TECHNOLOGY CANTON, NEW YORK COURSE OUTLINE VSCT 210 VETERINARY MICROBIOLOGY Prepared By: Mary O Horo Loomis, DVM SCHOOL OF SCIENCE, HEALTH AND CRIMINAL JUSTICE VETERINARY
STATE UNIVERSITY OF NEW YORK COLLEGE OF TECHNOLOGY CANTON, NEW YORK COURSE OUTLINE VSCT 210 VETERINARY MICROBIOLOGY Prepared By: Mary O Horo Loomis, DVM SCHOOL OF SCIENCE, HEALTH AND CRIMINAL JUSTICE VETERINARY
7- Master s Degree in Public Health and Public Health Sciences (Majoring Microbiology)
 7- Master s Degree in Public Health and Public Health Sciences (Majoring Microbiology) Students should fulfill a total of 38 credit hours: 1- Basic requirements: 10 credit hours. 150701, 150702, 150703,
7- Master s Degree in Public Health and Public Health Sciences (Majoring Microbiology) Students should fulfill a total of 38 credit hours: 1- Basic requirements: 10 credit hours. 150701, 150702, 150703,
PACT. PACT Nail Fungus Therapy Treatment Instructions. Photodynamic therapy for nail fungus using light, safely and gently.
 PACT PACT Nail Fungus Therapy Treatment Instructions Photodynamic therapy for nail fungus using light, safely and gently. PACT Nail Fungus Therapy Treatment Instructions Contents 1. Introduction 2. Nail
PACT PACT Nail Fungus Therapy Treatment Instructions Photodynamic therapy for nail fungus using light, safely and gently. PACT Nail Fungus Therapy Treatment Instructions Contents 1. Introduction 2. Nail
FOUR-YEAR DEGREE PROGRAMME I MICROBIOLOGY YEAR I
 FOUR-YEAR DEGREE PROGRAMME I MICROBIOLOGY YEAR I FSC 101 Introductory Biology 3 FSC 102 Introductory Chemistry 3 FSC 103 Introductory Computer Science 2 FSC 104 Introductory Mathematics 3 FSC 105 Introductory
FOUR-YEAR DEGREE PROGRAMME I MICROBIOLOGY YEAR I FSC 101 Introductory Biology 3 FSC 102 Introductory Chemistry 3 FSC 103 Introductory Computer Science 2 FSC 104 Introductory Mathematics 3 FSC 105 Introductory
A t f e t r e r th t is s lec e t c u t re r e t h t e e st s u t den e t t sh s ould b e e a b a le e t o t :
 Dermatopharmacology Prof Werner Sinclair Department of Dermatology University of the Free State Outcomes for this Lecture After this lecture the student should be able to: Name the most important characteristics
Dermatopharmacology Prof Werner Sinclair Department of Dermatology University of the Free State Outcomes for this Lecture After this lecture the student should be able to: Name the most important characteristics
WHY IS THIS IMPORTANT?
 CHAPTER 1 WHAT IS MICROBIOLOGY AND WHY IS IT IMPORTANT? WHO / TDR / Crump WHY IS THIS IMPORTANT? Microbiology is more relevant than ever in today s world. Infectious diseases are a leading health-related
CHAPTER 1 WHAT IS MICROBIOLOGY AND WHY IS IT IMPORTANT? WHO / TDR / Crump WHY IS THIS IMPORTANT? Microbiology is more relevant than ever in today s world. Infectious diseases are a leading health-related
Leukocytoclastic Vasculitis and Stasis Dermatitis With Id Reaction
 Id Reaction December 01, 2007 By David L. Kaplan, MD [1] A Photo Quiz to Hone Dermatologic Skills Case 1: A slightly pruritic eruption developed on the lower legs of a 39-year-old woman after she had an
Id Reaction December 01, 2007 By David L. Kaplan, MD [1] A Photo Quiz to Hone Dermatologic Skills Case 1: A slightly pruritic eruption developed on the lower legs of a 39-year-old woman after she had an
The dermatophytes Fungi that stalk you and your loved ones as their petri plate
 The dermatophytes Fungi that stalk you and your loved ones as their petri plate Dr. Richard Summerbell Dalla Lana School of Public Health, University of Toronto Geraldine Kaminski Medical Mycology Library
The dermatophytes Fungi that stalk you and your loved ones as their petri plate Dr. Richard Summerbell Dalla Lana School of Public Health, University of Toronto Geraldine Kaminski Medical Mycology Library
NIZORAL (KETOCONAZOLE) 2% SHAMPOO DESCRIPTION
 NIZORAL (KETOCONAZOLE) 2% SHAMPOO DESCRIPTION NIZORAL (ketoconazole) 2% Shampoo is a red-orange liquid for topical application, containing the broad spectrum synthetic antifungal agent ketoconazole in
NIZORAL (KETOCONAZOLE) 2% SHAMPOO DESCRIPTION NIZORAL (ketoconazole) 2% Shampoo is a red-orange liquid for topical application, containing the broad spectrum synthetic antifungal agent ketoconazole in
PROGRAMME SPECIFICATION
 PROGRAMME SPECIFICATION Awarding body/institution: Queen Mary, University of London Teaching institution (if different from above): Centre for Infectious Disease, Institute of Cell and Molecular Science,
PROGRAMME SPECIFICATION Awarding body/institution: Queen Mary, University of London Teaching institution (if different from above): Centre for Infectious Disease, Institute of Cell and Molecular Science,
Laser Treatment for Toenail Fungus
 Laser Treatment for Toenail Fungus Laser therapy is the newest treatment we offer for fungal toenails and effectively kills the fungus and clears the nails in many patients. The laser works by penetrating
Laser Treatment for Toenail Fungus Laser therapy is the newest treatment we offer for fungal toenails and effectively kills the fungus and clears the nails in many patients. The laser works by penetrating
Secondary bacterial infections complicating skin lesions
 J. Med. Microbiol. Vol. 51 (2002), 808 812 # 2002 Society for General Microbiology ISSN 0022-2615 REVIEW ARTICLE Secondary bacterial infections complicating skin lesions ITZHAK BROOK Department of Pediatrics,
J. Med. Microbiol. Vol. 51 (2002), 808 812 # 2002 Society for General Microbiology ISSN 0022-2615 REVIEW ARTICLE Secondary bacterial infections complicating skin lesions ITZHAK BROOK Department of Pediatrics,
Integumentary System Answer Key
 Answer Key Free PDF ebook Download: Answer Key Download or Read Online ebook integumentary system answer key in PDF Format From The Best User Guide Database the major organs and functions of the integumentary
Answer Key Free PDF ebook Download: Answer Key Download or Read Online ebook integumentary system answer key in PDF Format From The Best User Guide Database the major organs and functions of the integumentary
Course Curriculum for Master Degree in Medical Laboratory Sciences/Clinical Microbiology, Immunology and Serology
 Course Curriculum for Master Degree in Medical Laboratory Sciences/Clinical Microbiology, Immunology and Serology The Master Degree in Medical Laboratory Sciences / Clinical Microbiology, Immunology or
Course Curriculum for Master Degree in Medical Laboratory Sciences/Clinical Microbiology, Immunology and Serology The Master Degree in Medical Laboratory Sciences / Clinical Microbiology, Immunology or
Cutaneous Lymphoma FAST FACTS
 Cutaneous Lymphoma FAST FACTS What is Cutaneous Lymphoma? Cutaneous lymphomas are types of non-hodgkin s lymphomas (NHL) that originate in the lymphocytes (white blood cells). Unlike most other types of
Cutaneous Lymphoma FAST FACTS What is Cutaneous Lymphoma? Cutaneous lymphomas are types of non-hodgkin s lymphomas (NHL) that originate in the lymphocytes (white blood cells). Unlike most other types of
Candida: The Fungus among Us
 1 Candida: The Fungus among Us The causative agent of the Candidiasis disease is a fungus Candida, usually Candida albicans. Candida are thin-walled, small yeast (4 to 6 microns) that reproduce by budding
1 Candida: The Fungus among Us The causative agent of the Candidiasis disease is a fungus Candida, usually Candida albicans. Candida are thin-walled, small yeast (4 to 6 microns) that reproduce by budding
The Future of Dermatology Practice. Steven Grekin, D.O., F.A.O.C.D.
 The Future of Dermatology Practice Steven Grekin, D.O., F.A.O.C.D. Objectives To discuss: New medications which have come to market in the past 12 months Upcoming changes to physician reimbursement models
The Future of Dermatology Practice Steven Grekin, D.O., F.A.O.C.D. Objectives To discuss: New medications which have come to market in the past 12 months Upcoming changes to physician reimbursement models
Chapter 71. Caring for Clients with Skin, Hair and Nail Disorders. Tattoos & Body Piercing
 Chapter 71 Caring for Clients with Skin, Hair and Nail Disorders Tattoos & Body Piercing A Tattoois pigmentation of the dermal layer of the skin with needles containing dye Body piercing is the insertion
Chapter 71 Caring for Clients with Skin, Hair and Nail Disorders Tattoos & Body Piercing A Tattoois pigmentation of the dermal layer of the skin with needles containing dye Body piercing is the insertion
The Immune System. 2 Types of Defense Mechanisms. Lines of Defense. Line of Defense. Lines of Defense
 The Immune System 2 Types of Defense Mechanisms Immune System the system that fights infection by producing cells to inactivate foreign substances to avoid infection and disease. Immunity the body s ability
The Immune System 2 Types of Defense Mechanisms Immune System the system that fights infection by producing cells to inactivate foreign substances to avoid infection and disease. Immunity the body s ability
Single-celled microorganisms, which can live inside or outside the body. Some cause sickness, but others are harmless.
 The Science behind the Noses are Red show: Introduction: The Noses are Red show is about allergies and the biological causes behind them. In order to explain allergies you need to understand a certain
The Science behind the Noses are Red show: Introduction: The Noses are Red show is about allergies and the biological causes behind them. In order to explain allergies you need to understand a certain
Sports Dermatology. Atlantic Sports Health Damion A. Martins, MD Director Dean Padavan, MD Brett Keller, MD
 Sports Dermatology Atlantic Sports Health Damion A. Martins, MD Director Dean Padavan, MD Brett Keller, MD Objectives NJSIAA Skin Checks Disease Identification and Management Bacterial Fungal Viral Return
Sports Dermatology Atlantic Sports Health Damion A. Martins, MD Director Dean Padavan, MD Brett Keller, MD Objectives NJSIAA Skin Checks Disease Identification and Management Bacterial Fungal Viral Return
Skin Infections and Infestations
 Campen_C05.qxd 23/04/2004 05:25 PM Page 67 Chapter 5 Ch. 5: Skin Infections and Infestations 67 Skin Infections and Infestations FUNGAL INFECTIONS OF SKIN Most fungi that infect the stratum corneum of
Campen_C05.qxd 23/04/2004 05:25 PM Page 67 Chapter 5 Ch. 5: Skin Infections and Infestations 67 Skin Infections and Infestations FUNGAL INFECTIONS OF SKIN Most fungi that infect the stratum corneum of
Two main classes: Epithelial Connective (synovial) Epithelial. Cutaneous Mucous Serous
 Two main classes: Epithelial Connective (synovial) Epithelial Cutaneous Mucous Serous Epithelial Membranes = sheet of epithelia + connective tissue base 1. Cutaneous membrane: outer skin layer (stratified
Two main classes: Epithelial Connective (synovial) Epithelial Cutaneous Mucous Serous Epithelial Membranes = sheet of epithelia + connective tissue base 1. Cutaneous membrane: outer skin layer (stratified
A: Nursing Knowledge. Alberta Licensed Practical Nurses Competency Profile 1
 A: Nursing Knowledge Alberta Licensed Practical Nurses Competency Profile 1 Competency: A-1 Anatomy and Physiology A-1-1 A-1-2 A-1-3 A-1-4 A-1-5 A-1-6 A-1-7 A-1-8 Identify the normal structures and functions
A: Nursing Knowledge Alberta Licensed Practical Nurses Competency Profile 1 Competency: A-1 Anatomy and Physiology A-1-1 A-1-2 A-1-3 A-1-4 A-1-5 A-1-6 A-1-7 A-1-8 Identify the normal structures and functions
Common Skin Conditions in Children. Liz Moore and Emma King Dermatology Nurse Consultants
 Common Skin Conditions in Children Liz Moore and Emma King Dermatology Nurse Consultants Diagnosis? Nummular Dermatitis Disc pattern rash (discoid eczema) Clearly demarcated edges Occurs at any age Can
Common Skin Conditions in Children Liz Moore and Emma King Dermatology Nurse Consultants Diagnosis? Nummular Dermatitis Disc pattern rash (discoid eczema) Clearly demarcated edges Occurs at any age Can
Fast and reliable PCR/sequencing/RFLP assay for identification of fungi in onychomycoses
 Journal of Medical Microbiology (2006), 55, 1211 1216 DOI 10.1099/jmm.0.46723-0 Fast and reliable PCR/sequencing/RFLP assay for identification of fungi in onychomycoses Michel Monod, Olympia Bontems, Christophe
Journal of Medical Microbiology (2006), 55, 1211 1216 DOI 10.1099/jmm.0.46723-0 Fast and reliable PCR/sequencing/RFLP assay for identification of fungi in onychomycoses Michel Monod, Olympia Bontems, Christophe
How antifungal drugs kill fungi and cure disease
 How antifungal drugs kill fungi and cure disease Snake-oil Salesmen New Product Devours Candida-Yeast Without Major Dietary Change Do you suffer from depression, anxiety, irritability, heartburn, indigestion
How antifungal drugs kill fungi and cure disease Snake-oil Salesmen New Product Devours Candida-Yeast Without Major Dietary Change Do you suffer from depression, anxiety, irritability, heartburn, indigestion
X-Plain Alopecia Reference Summary
 X-Plain Alopecia Reference Summary Introduction Hair loss is very common in both men and women. You or someone you love may be experiencing hair loss. Hair follicle Learning about normal hair growth is
X-Plain Alopecia Reference Summary Introduction Hair loss is very common in both men and women. You or someone you love may be experiencing hair loss. Hair follicle Learning about normal hair growth is
Medical/Clinical Assistant CIP 51.0801 Task Grid
 1 Secondary Task List 100 PHARMACOLOGY 101 Measure drug dosages using droppers, medicine cups, syringes, and other specialized devices. 102 Utilize correct technique to administer medications using the
1 Secondary Task List 100 PHARMACOLOGY 101 Measure drug dosages using droppers, medicine cups, syringes, and other specialized devices. 102 Utilize correct technique to administer medications using the
AUS DEM SCHWEIZERISCHEN TROPENINSTITUT BASEL UND DER UNIVERSITÄTS-HAUTKLINIK
 AUS DEM SCHWEIZERISCHEN TROPENINSTITUT BASEL UND DER UNIVERSITÄTS-HAUTKLINIK DER ALBERT-LUDWIGS-UNIVERSITÄT FREIBURG I.BR. EFFICACY OF TRICLOSAN SOAP AGAINST SUPERFICIAL DERMATOMYCOSES AND SCABIES - A
AUS DEM SCHWEIZERISCHEN TROPENINSTITUT BASEL UND DER UNIVERSITÄTS-HAUTKLINIK DER ALBERT-LUDWIGS-UNIVERSITÄT FREIBURG I.BR. EFFICACY OF TRICLOSAN SOAP AGAINST SUPERFICIAL DERMATOMYCOSES AND SCABIES - A
Unit/Standard Number. Proficiency Level Achieved: (X) Indicates Competency Achieved to Industry Proficiency Level
 1 Secondary Task List 100 INTRODUCTION TO HEALTHCARE 101 Identify the roles and educational/credentialing requirements of various health care practitioners. 102 Describe the 's job description, personal
1 Secondary Task List 100 INTRODUCTION TO HEALTHCARE 101 Identify the roles and educational/credentialing requirements of various health care practitioners. 102 Describe the 's job description, personal
Preparation "Clinical Laboratory Technologist and Technician Overview"
 Clinical Laboratory Technologist and Technician Overview The Field - Preparation - Day in the Life - Earnings - Employment - Career Path Forecast - Professional Organizations The Field Clinical laboratory
Clinical Laboratory Technologist and Technician Overview The Field - Preparation - Day in the Life - Earnings - Employment - Career Path Forecast - Professional Organizations The Field Clinical laboratory
University of Babylon College of Dentistry Curriculum of first Year
 University of Babylon College of Dentistry Curriculum of first Year The Name of Course Medical Chemistery The Number of Course Me. Ch 100 Number of unite 8 Total Hours 5 Theory Hours 3 5% 5% 10% 20% ---
University of Babylon College of Dentistry Curriculum of first Year The Name of Course Medical Chemistery The Number of Course Me. Ch 100 Number of unite 8 Total Hours 5 Theory Hours 3 5% 5% 10% 20% ---
PRODUCT MONOGRAPH KETODERM
 PRODUCT MONOGRAPH KETODERM Cream 2% (Ketoconazole, USP) Topical Antifungal Agent TaroPharma A Division of Taro Pharmaceuticals Inc. 130 East Drive Brampton, Ontario L6T 1C1 Preparation Date: Control #
PRODUCT MONOGRAPH KETODERM Cream 2% (Ketoconazole, USP) Topical Antifungal Agent TaroPharma A Division of Taro Pharmaceuticals Inc. 130 East Drive Brampton, Ontario L6T 1C1 Preparation Date: Control #
Nursing college, Second stage Microbiology Dr.Nada Khazal K. Hendi L14: Hospital acquired infection, nosocomial infection
 L14: Hospital acquired infection, nosocomial infection Definition A hospital acquired infection, also called a nosocomial infection, is an infection that first appears between 48 hours and four days after
L14: Hospital acquired infection, nosocomial infection Definition A hospital acquired infection, also called a nosocomial infection, is an infection that first appears between 48 hours and four days after
STOP HAIR LOSS DR JOYCE LIM DERMATOLOGIST PARAGON MEDICAL CENTRE #11-16/20
 STOP HAIR LOSS DR JOYCE LIM DERMATOLOGIST PARAGON MEDICAL CENTRE #11-16/20 HAIR LOSS Types of Hair loss What causes them What are the solutions HAIR LOSS PATCHY HAIR LOSS PATCHY HAIR LOSS Single/ Multiple
STOP HAIR LOSS DR JOYCE LIM DERMATOLOGIST PARAGON MEDICAL CENTRE #11-16/20 HAIR LOSS Types of Hair loss What causes them What are the solutions HAIR LOSS PATCHY HAIR LOSS PATCHY HAIR LOSS Single/ Multiple
FACULTY OF MEDICAL SCIENCE
 Doctor of Philosophy Program in Microbiology FACULTY OF MEDICAL SCIENCE Naresuan University 171 Doctor of Philosophy Program in Microbiology The time is critical now for graduate education and research
Doctor of Philosophy Program in Microbiology FACULTY OF MEDICAL SCIENCE Naresuan University 171 Doctor of Philosophy Program in Microbiology The time is critical now for graduate education and research
Registered Nurse Series Final Classification Standards December 2007
 Final Classification Standards December 2007 Series Overview This series is comprised of three classifications with progressive responsibility for nursing care and services and administrative duties within
Final Classification Standards December 2007 Series Overview This series is comprised of three classifications with progressive responsibility for nursing care and services and administrative duties within
Foot & Ankle Center of Washington Laser Treatment of Toenail Fungus Financial Information
 Foot & Ankle Center of Washington Laser Treatment of Toenail Fungus Financial Information Insurance Coverage Insurance companies consider laser therapy a cosmetic procedure and do not cover the service.
Foot & Ankle Center of Washington Laser Treatment of Toenail Fungus Financial Information Insurance Coverage Insurance companies consider laser therapy a cosmetic procedure and do not cover the service.
Laser Treatment of Onychomycosis
 Laser Treatment of Onychomycosis Policy Number: 2.01.89 Last Review: 11/2015 Origination: 11/2015 Next Review: 5/2016 Policy Blue Cross and Blue Shield of Kansas City (Blue KC) will not provide coverage
Laser Treatment of Onychomycosis Policy Number: 2.01.89 Last Review: 11/2015 Origination: 11/2015 Next Review: 5/2016 Policy Blue Cross and Blue Shield of Kansas City (Blue KC) will not provide coverage
How Does a Doctor Test for AIDS?
 Edvo-Kit #S-70 How Does a Doctor Test for AIDS? S-70 Experiment Objective: The Human Immunodefi ciency Virus (HIV) is an infectious agent that causes Acquired Immunodefi ciency Syndrome (AIDS) in humans.
Edvo-Kit #S-70 How Does a Doctor Test for AIDS? S-70 Experiment Objective: The Human Immunodefi ciency Virus (HIV) is an infectious agent that causes Acquired Immunodefi ciency Syndrome (AIDS) in humans.
Required Text: Tortora, Funke, and Case. Microbiology, An Introduction, 9 th ed. Benjamin Cummings, 2007.
 Department of Biology Introduction to Microbiology Biol 132 (3 credit hours) Dr. Kathryn Sutton, Assistant Professor of Biology Spring, 2007 M 9-9:50; CBH Room 203 General Information Office Location CBH
Department of Biology Introduction to Microbiology Biol 132 (3 credit hours) Dr. Kathryn Sutton, Assistant Professor of Biology Spring, 2007 M 9-9:50; CBH Room 203 General Information Office Location CBH
Most skin diseases occur in people of
 treating skin of color NATIONALLY-RECOGNIZED DERMATOLOGIST CHARLES E CRUTCHFIELD III MD DISCUSSES SOME COMMON SKIN DISORDERS OBSERVED IN SKIN OF COLOR. Most skin diseases occur in people of all nationalities,
treating skin of color NATIONALLY-RECOGNIZED DERMATOLOGIST CHARLES E CRUTCHFIELD III MD DISCUSSES SOME COMMON SKIN DISORDERS OBSERVED IN SKIN OF COLOR. Most skin diseases occur in people of all nationalities,
What are Stem Cells? How can they be used in medicine?
 What are Stem Cells? How can they be used in medicine? What is a stem cell????... What is a stem cell????......a cell with the ability to differentiate into specialized cells and renew to become more stem
What are Stem Cells? How can they be used in medicine? What is a stem cell????... What is a stem cell????......a cell with the ability to differentiate into specialized cells and renew to become more stem
Juvenile Dermatomyositis Joseph Junewick, MD FACR
 Juvenile Dermatomyositis Joseph Junewick, MD FACR 10/11/2015 History Child with several month history of weakness, arthralgias and palpable abnormalities at the knee Diagnosis Juvenile Dermatomyositis
Juvenile Dermatomyositis Joseph Junewick, MD FACR 10/11/2015 History Child with several month history of weakness, arthralgias and palpable abnormalities at the knee Diagnosis Juvenile Dermatomyositis
Before you know about your future see your past before improving your future hair see what has been and is the state of your hair now Ravi Bhanot
 Chapter 1 All you need to know about hair almost Before you know about your future see your past before improving your future hair see what has been and is the state of your hair now Ravi Bhanot Typically
Chapter 1 All you need to know about hair almost Before you know about your future see your past before improving your future hair see what has been and is the state of your hair now Ravi Bhanot Typically
Approaches to Infection Control
 Approaches to Infection Control Considerations for PTAs in the Clinic Objectives Describe the basic characteristics of bacteria, viruses, fungi, and parasites. Discuss the locations, advantages, and disadvantages
Approaches to Infection Control Considerations for PTAs in the Clinic Objectives Describe the basic characteristics of bacteria, viruses, fungi, and parasites. Discuss the locations, advantages, and disadvantages
Please visit your examination provider s website for the most current bulletin prior to testing. IMPORTANT INSTRUCTIONS
 NATIONAL BARBER THEORY EXAMINATION CANDIDATE INFORMATION BULLETIN Please visit your examination provider s website for the most current bulletin prior to testing. The National Barber Theory Examination
NATIONAL BARBER THEORY EXAMINATION CANDIDATE INFORMATION BULLETIN Please visit your examination provider s website for the most current bulletin prior to testing. The National Barber Theory Examination
COMPOUNDING PHARMACY SOLUTIONS PRESCRIPTION COMPOUNDING FOR DERMATOLOGY
 JUNE 2012 COMPOUNDING PHARMACY SOLUTIONS PRESCRIPTION COMPOUNDING WWW.CPSRXS. COM We customize individual prescriptions for the specific needs of our patients. INSIDE THIS ISSUE: Acne 2 Cutaneous Candidiasis
JUNE 2012 COMPOUNDING PHARMACY SOLUTIONS PRESCRIPTION COMPOUNDING WWW.CPSRXS. COM We customize individual prescriptions for the specific needs of our patients. INSIDE THIS ISSUE: Acne 2 Cutaneous Candidiasis
Laser treatment for toenail fungus
 Laser treatment for toenail fungus David M. Harris a,b, Brian A. McDowell c, John Strisower b, a Univ. of Washington, Seattle WA, USA 98195; b PathoLase, Inc. 275 Airpark Blvd., Chico, CA 95973; c Northern
Laser treatment for toenail fungus David M. Harris a,b, Brian A. McDowell c, John Strisower b, a Univ. of Washington, Seattle WA, USA 98195; b PathoLase, Inc. 275 Airpark Blvd., Chico, CA 95973; c Northern
What actually is the immune system? What is it made up of?
 This is a radio interview with Ken Sell, M.D., scientific director of the National Institute of Allergy and Infectious Diseases, National Institutes of Health (NIH), and Co-Chairman of the NIH Working
This is a radio interview with Ken Sell, M.D., scientific director of the National Institute of Allergy and Infectious Diseases, National Institutes of Health (NIH), and Co-Chairman of the NIH Working
PROPERTIES OF THE HAIR AND SCALP
 PROPERTIES OF THE HAIR AND SCALP 1. The scientific study of hair, its diseases and care is called: a. dermatology c. biology b. trichology d. cosmetology 2. The two parts of a mature hair strand are the
PROPERTIES OF THE HAIR AND SCALP 1. The scientific study of hair, its diseases and care is called: a. dermatology c. biology b. trichology d. cosmetology 2. The two parts of a mature hair strand are the
Immunity Unit Test Z
 Immunity Unit Test Z Name MB Multiple Choice Identify the choice that best completes the statement or answers the question. 1. Which of the pathogens in Figure 31.1 cause disease by taking over healthy
Immunity Unit Test Z Name MB Multiple Choice Identify the choice that best completes the statement or answers the question. 1. Which of the pathogens in Figure 31.1 cause disease by taking over healthy
Interactive Programs. genrmedia.com. 845 Third Avenue, 6th Floor New York, New York 10022 [email protected]
 Interactive Programs genrmedia.com 845 Third Avenue, 6th Floor New York, New York 10022 [email protected] Online Initiatives As innovators in digital media and marketing, GenR Media offers a suite of
Interactive Programs genrmedia.com 845 Third Avenue, 6th Floor New York, New York 10022 [email protected] Online Initiatives As innovators in digital media and marketing, GenR Media offers a suite of
In vitro activity of Melaleuca alternifolia (tea tree) oil against dermatophytes and other filamentous fungi
 Journal of Antimicrobial Chemotherapy (2002) 50, 195 199 DOI: 10.1093/jac/dkf112 In vitro activity of Melaleuca alternifolia (tea tree) oil against dermatophytes and other filamentous fungi K. A. Hammer
Journal of Antimicrobial Chemotherapy (2002) 50, 195 199 DOI: 10.1093/jac/dkf112 In vitro activity of Melaleuca alternifolia (tea tree) oil against dermatophytes and other filamentous fungi K. A. Hammer
Name Date Class. This section explains what kinds of organisms cause infectious disease and how infectious diseases are spread.
 Fighting Disease Name Date Class Infectious Disease This section explains what kinds of organisms cause infectious disease and how infectious diseases are spread. Use Target Reading Skills Before you read,
Fighting Disease Name Date Class Infectious Disease This section explains what kinds of organisms cause infectious disease and how infectious diseases are spread. Use Target Reading Skills Before you read,
FastTest. You ve read the book... ... now test yourself
 FastTest You ve read the book...... now test yourself To ensure you have learned the key points that will improve your patient care, read the authors questions below. Please refer back to relevant sections
FastTest You ve read the book...... now test yourself To ensure you have learned the key points that will improve your patient care, read the authors questions below. Please refer back to relevant sections
Smoothbeam Laser Treatment of Acne Vulgaris. Emerging Applications
 Smoothbeam Laser Treatment of Acne Vulgaris Emerging Applications About Acne Vulgaris Very common - Affects 80% of population Almost every person experiences acne Most common reason to visit dermatologist
Smoothbeam Laser Treatment of Acne Vulgaris Emerging Applications About Acne Vulgaris Very common - Affects 80% of population Almost every person experiences acne Most common reason to visit dermatologist
Bachelor of Nursing Programme
 Bachelor of Nursing Programme 1 Bachelor of Nursing Programme This is a four-year full-time undergraduate nursing degree programme. Graduates of this programme will be prepared for registration as General
Bachelor of Nursing Programme 1 Bachelor of Nursing Programme This is a four-year full-time undergraduate nursing degree programme. Graduates of this programme will be prepared for registration as General
PUBLIC HEALTH PARASITOLOGY PHC 6513 Syllabus, Spring Semester 2014
 PUBLIC HEALTH PARASITOLOGY PHC 6513 Syllabus, Spring Semester 2014 Location: Conference Room and the Don Price Lab, William G. Doc Myers Building, 3602 Spectrum Blvd (see map below) Course Director: Professor
PUBLIC HEALTH PARASITOLOGY PHC 6513 Syllabus, Spring Semester 2014 Location: Conference Room and the Don Price Lab, William G. Doc Myers Building, 3602 Spectrum Blvd (see map below) Course Director: Professor
SWISS SOCIETY OF NEONATOLOGY. Congenital cutaneous candidiasis (CCC): a rare skin disorder of the neonate
 SWISS SOCIETY OF NEONATOLOGY Congenital cutaneous candidiasis (CCC): a rare skin disorder of the neonate April 2003 2 Diana A, Martin G, Ecoffey M, and Pfister R, Department of Pediatrics and Department
SWISS SOCIETY OF NEONATOLOGY Congenital cutaneous candidiasis (CCC): a rare skin disorder of the neonate April 2003 2 Diana A, Martin G, Ecoffey M, and Pfister R, Department of Pediatrics and Department
Mini-Medical School on Infectious Diseases. Session #1 - Basic Science
 Mini-Medical School on Infectious Diseases Session #1 - Basic Science The Microbial World Michael V. Norgard, Ph.D., Chairman Department of Microbiology U.T. Southwestern Medical Center The Microbial World
Mini-Medical School on Infectious Diseases Session #1 - Basic Science The Microbial World Michael V. Norgard, Ph.D., Chairman Department of Microbiology U.T. Southwestern Medical Center The Microbial World
Class Im MD A novel device for Automated Analysis of Tear Film Dynamics. Michael Ring, DI(FH) Upper Austria University of Applied Sciences
 Class Im MD A novel device for Automated Analysis of Tear Film Dynamics Michael Ring, DI(FH) Upper Austria University of Applied Sciences Aim of the Research Develop a method to give information on the
Class Im MD A novel device for Automated Analysis of Tear Film Dynamics Michael Ring, DI(FH) Upper Austria University of Applied Sciences Aim of the Research Develop a method to give information on the
PRIORITY RESEARCH TOPICS
 PRIORITY RESEARCH TOPICS Understanding all the issues associated with antimicrobial resistance is probably impossible, but it is clear that there are a number of key issues about which we need more information.
PRIORITY RESEARCH TOPICS Understanding all the issues associated with antimicrobial resistance is probably impossible, but it is clear that there are a number of key issues about which we need more information.
Doctoral Program Department of Microbiology and Immunology
 Doctoral Program Department of Microbiology and Immunology (05/12/2011 revised) Graduate studies in the Department of Microbiology and Immunology are designed to provide the doctoral student with a broad
Doctoral Program Department of Microbiology and Immunology (05/12/2011 revised) Graduate studies in the Department of Microbiology and Immunology are designed to provide the doctoral student with a broad
Infection control. Self-study course
 Infection control Self-study course Course objectives By the end of this course you will be able to: 1) Define a germ 2) Define the environment that a germ needs to live and grow 3) Explain the chain of
Infection control Self-study course Course objectives By the end of this course you will be able to: 1) Define a germ 2) Define the environment that a germ needs to live and grow 3) Explain the chain of
Common Dermatological Problems
 Slide 1 Common Dermatological Problems Papulosquamous Diseases Papulosquamous diseases are a group of disorders characterized by scaly papules and plaques. These entities have little in common except the
Slide 1 Common Dermatological Problems Papulosquamous Diseases Papulosquamous diseases are a group of disorders characterized by scaly papules and plaques. These entities have little in common except the
Develop a specialist who is capable of correlation of basic sciences and clinical sciences, and challenge the requirements for certification.
 Course Specification Faculty : Dentistry Department : Endodontics Program Specification: Diploma Degree A-Basic Information 1-Programme Title: Diploma in Endodontics 2-Departments (s): Endodontics 4-Coordinator:
Course Specification Faculty : Dentistry Department : Endodontics Program Specification: Diploma Degree A-Basic Information 1-Programme Title: Diploma in Endodontics 2-Departments (s): Endodontics 4-Coordinator:
The Integumentary System Dr. Ali Ebneshahidi
 The Integumentary System Dr. Ali Ebneshahidi The Skin The integument system consists of the skin (cutaneous membrane) and its accessory organs. The skin is composed of three layers of tissue: the outer
The Integumentary System Dr. Ali Ebneshahidi The Skin The integument system consists of the skin (cutaneous membrane) and its accessory organs. The skin is composed of three layers of tissue: the outer
Do I need a physician referral? Yes, we see patients on referral from a health care provider.
 FAQS FOR OFFICE POLICIES How do I get an appointment? New appointments are made by physician referral only. Your referring health care provided will call for the appointment for you. What do I need to
FAQS FOR OFFICE POLICIES How do I get an appointment? New appointments are made by physician referral only. Your referring health care provided will call for the appointment for you. What do I need to
B. Disorders of sebaceous glands
 Go Back to the Top To Order, Visit the Purchasing Page for Details B. Disorders of sebaceous glands 1. Acne vulgaris It most frequently occurs on the face of adolescent men and women. Comedones, folliculitis,
Go Back to the Top To Order, Visit the Purchasing Page for Details B. Disorders of sebaceous glands 1. Acne vulgaris It most frequently occurs on the face of adolescent men and women. Comedones, folliculitis,
NATIONAL HAZARD EXPOSURE WORKER SURVEILLANCE:
NATIONAL HAZARD EXPOSURE WORKER SURVEILLANCE: EXPOSURE TO BIOLOGICAL HAZARDS AND THE PROVISION OF CONTROLS AGAINST BIOLOGICAL HAZARDS IN AUSTRALIAN WORKPLACES MARCH 2011 National Hazard Exposure Worker
NATIONAL HAZARD EXPOSURE WORKER SURVEILLANCE: EXPOSURE TO BIOLOGICAL HAZARDS AND THE PROVISION OF CONTROLS AGAINST BIOLOGICAL HAZARDS IN AUSTRALIAN WORKPLACES MARCH 2011 National Hazard Exposure Worker
Modifiers Q7, Q8, and Q9
 1-47 Modifiers Q7, Q8, and Q9 (Routine Foot Care) CPT Modifier Q7 One Class A finding Q8 Two Class B findings Q9 One Class B and two Class C findings General Information The Office of Inspector General
1-47 Modifiers Q7, Q8, and Q9 (Routine Foot Care) CPT Modifier Q7 One Class A finding Q8 Two Class B findings Q9 One Class B and two Class C findings General Information The Office of Inspector General
A guide to diagnosing skin infections in practice
 A guide to diagnosing skin infections in practice Special Thanks Pfi zer Animal Health would like to thank the following people for kindly supplying the images for this booklet and without whose support
A guide to diagnosing skin infections in practice Special Thanks Pfi zer Animal Health would like to thank the following people for kindly supplying the images for this booklet and without whose support
Notes on Hair Analysis
 Notes on Hair Analysis I have found local veterinarians very uncooperative when trying to get samples of dog and cat fur. I have found neighbors, friends and relatives a much better source of fur. There
Notes on Hair Analysis I have found local veterinarians very uncooperative when trying to get samples of dog and cat fur. I have found neighbors, friends and relatives a much better source of fur. There
Successful Treatment of Trichophytonrubrum Onychomycosis and Warts (Verruca Plantae) with BioCool
 Successful Treatment of Trichophytonrubrum Onychomycosis and Warts (Verruca Plantae) with BioCool Gunnar Sandström 1, J-O Eriksson 2 and Amir Saeed 1 1 Karolinska Institute, Department of Laboratory Medicine,
Successful Treatment of Trichophytonrubrum Onychomycosis and Warts (Verruca Plantae) with BioCool Gunnar Sandström 1, J-O Eriksson 2 and Amir Saeed 1 1 Karolinska Institute, Department of Laboratory Medicine,
THERAPY FOR THE SKIN Non-allergenic and Non-sensitizing
 THERAPY FOR THE SKIN Non-allergenic and Non-sensitizing FOR CLINICAL INFORMATION ABOUT OUR PRODUCTS, CALL 877.611.0081. TO ORDER, VISIT MMS.MCKESSON.COM OR CALL YOUR MCKESSON MEDICAL-SURGICAL ACCOUNT MANAGER.
THERAPY FOR THE SKIN Non-allergenic and Non-sensitizing FOR CLINICAL INFORMATION ABOUT OUR PRODUCTS, CALL 877.611.0081. TO ORDER, VISIT MMS.MCKESSON.COM OR CALL YOUR MCKESSON MEDICAL-SURGICAL ACCOUNT MANAGER.
CAREERS IN BIOMEDICAL SCIENCE & THE IBMS. Betty Kyle Scottish Regional Representative IBMS Lead Biomedical Scientist NHS Lanarkshire
 CAREERS IN BIOMEDICAL SCIENCE & THE IBMS Betty Kyle Scottish Regional Representative IBMS Lead Biomedical Scientist NHS Lanarkshire What is a biomedical scientist? Biomedical scientists carry out investigations
CAREERS IN BIOMEDICAL SCIENCE & THE IBMS Betty Kyle Scottish Regional Representative IBMS Lead Biomedical Scientist NHS Lanarkshire What is a biomedical scientist? Biomedical scientists carry out investigations
